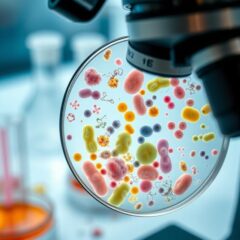
Choroby bakteryjne: przyczyny, objawy i metody leczenia

Endodoncja: jak wygląda leczenie chorób miazgi zębowej?
Endodoncja, znana jako leczenie kanałowe, to kluczowy obszar stomatologii, który skupia się na ratowaniu zębów dotkniętych chorobami miazgi oraz infekcjami. Czy wiesz, że skuteczne leczenie endodontyczne może uratować zęby, które w przeciwnym razie musiałyby zostać usunięte? W miarę jak rośnie świadomość na temat zdrowia jamy ustnej, coraz więcej pacjentów decyduje się na skorzystanie z tej specjalistycznej formy pomocy. Diagnostyka i...
Gronkowiec – co musisz wiedzieć o zakażeniach i powikłaniach?
Gronkowce to bakterie, które nie tylko są naturalnym mieszkańcem naszej flory bakteryjnej, ale także mogą stać się groźnymi patogenami, wywołującymi szereg poważnych chorób. Szczególnie niebezpieczny jest gronkowiec złocisty, który może prowadzić do infekcji takich jak zapalenie płuc, bakteriemia, a nawet sepsa. Warto wiedzieć, że zakażenia gronkowcem mogą dotyczyć każdego z nas, a objawy mogą być różnorodne, w zależności od miejsca...
Grzybica skóry głowy: objawy, rodzaje i skuteczne leczenie
Grzybica skóry głowy to powszechna, ale często niedoceniana choroba, która może dotknąć zarówno dzieci, jak i dorosłych. Zakażenie wywołane przez grzyby dermatofitowe nie tylko powoduje dyskomfort, ale również prowadzi do poważnych problemów, takich jak wypadanie włosów czy stany zapalne. Często przenoszona przez bezpośredni kontakt lub wspólne przedmioty, grzybica może łatwo stać się problemem w grupach, zwłaszcza wśród najmłodszych....
Choroby bakteryjne: przyczyny, objawy i metody leczenia
Choroby bakteryjne stanowią poważne zagrożenie dla zdrowia, mimo że tylko niewielki procent znanych bakterii jest zdolny do wywoływania chorób. Zakażenia te mogą występować w różnych częściach ciała, wpływając na układ oddechowy, moczowy, pokarmowy oraz skórę, a ich objawy mogą być zarówno łagodne, jak i zagrażające życiu. W obliczu rosnącej oporności na antybiotyki, zrozumienie mechanizmów zakażeń bakteryjnych oraz sposobów ich...
Glicyna – właściwości, działanie i korzyści zdrowotne aminokwasu
Glicyna, najprostszy aminokwas endogenny, odgrywa kluczową rolę w naszym organizmie, wspierając zarówno układ trawienny, jak i odpornościowy. Stanowi około 11% wszystkich aminokwasów obecnych w ciele, a w kolagenie aż jedną trzecią jego składu. Dzięki swoim właściwościom, glicyna nie tylko wspomaga regenerację śluzówek, ale także działa uspokajająco, co czyni ją niezwykle interesującym związkiem dla osób zmagających się z lękiem czy...

Najnowsze komentarze